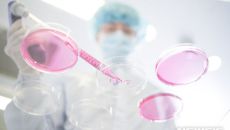

2026
일
월
화
수
목
금
토
-

'부상자 속출' KT, '알토란 활약' 이두원-이윤기 활약 빛났다[오!쎈수원]
[OSEN=수원, 우충원 기자] 부상자가 늘어나며 어려움이 많은 수원 KT가 백업선수들의 활약으로 승리를 맛봤다. 수원 KT는- 2026-01-12 07:02
- OSEN
-

매출 148% 껑충 인스파이어…외국인 카지노, 4파전 본격화
개장 3년 차를 맞은 인천 영종도 복합리조트 인스파이어 엔터테인먼트 리조트가 주력인 외국인 카지노 부문에서 괄목할 성장세를 보- 2026-01-12 07:02
- 아시아경제
-

"코치 학대 못 견뎌 4층 투신 폭로"…中 13세 체조 유망주의 비극
[파이낸셜뉴스] 중국의 13세 체조 유망주가 코치진의 가혹 행위를 견디다 못해 투신했다는 주장이 제기돼 파문이 일고 있다. 피- 2026-01-12 07:01
- 파이낸셜뉴스
-

젠슨 황 “AI종말론, 사회에 해악…‘AI 안전’ 투자조차 위축시켜” [1일1트]
[헤럴드경제=김영철 기자] 젠슨 황 엔비디아 최고경영자(CEO)가 기술업계에서 제기되는 ‘인공지능(AI) 종말론’에 대해 강도- 2026-01-12 07:01
- 헤럴드경제
-

CPI·대형은행 실적 주목…글로벌 지정학 불확실성 부각
(서울=뉴스1) 신기림 기자 = 뉴욕 증시가 새해 첫 주 거의 2% 상승했지만 기업 실적 시즌의 개막과 새로운 인플레이션 데이- 2026-01-12 07:01
- 뉴스1
-

대구시장 선거 '부익부 빈익빈'?…국힘은 후보 난립, 민주당은 인물난
(대구=뉴스1) 남승렬 기자 = 제1야당과 집권당의 6·3 지방선거 대구시장 선거 인물 구도가 '부익부 빈익빈' 양상을 보이고- 2026-01-12 07:01
- 뉴스1
-

광주·전남 행정통합 '운명의 한 주'…특별법 공청회 등 열려
(무안=뉴스1) 전원 기자 = 이재명 대통령의 지지를 얻은 광주·전남 행정통합 논의가 '운명의 한 주'를 맞았다. 이번 주 관- 2026-01-12 07:01
- 뉴스1
-
'새로운 작용' 비만 치료제 올해 나올까…빅파마 쟁탈전
[서울=뉴시스]송연주 기자 = 올해 새로운 작용기전의 차세대 비만 치료제가 처음 나올지 주목된다. 12일 제약업계에 따르면 노- 2026-01-12 07:01
- 뉴시스
-

[AM-PM] '언론사 단전·단수 지시 의혹' 이상민 결심공판 外
오늘(12일) 하루 주요 일정을 살펴보는 보도국 AM-PM입니다. 어떤 일정이 있는지 함께 보시겠습니다. ▶ '언론사 단전·단- 2026-01-12 07:00
- 연합뉴스TV
-

사랑의 눈으로 본다면…이 삶도 제법 살 만하지 않을까
겨울이니깐 붕어빵 먼저 먹어보자. 다음엔 풀빵, 군고구마 먹다 보면 봄이 오거든. 봄에는 예쁜 벚꽃이 피잖아. 그 벚꽃 보면서- 2026-01-12 07:00
- 한겨레
-

출근길 블랙아이스 비상…추돌사고·안전재난문자 잇따라
밤사이 급격히 떨어진 기온과 눈·비 여파가 겹치며 12일 아침 전국 곳곳에서 ‘블랙아이스(도로 살얼음)’로 인한 사고와 교통- 2026-01-12 07:00
- 이투데이
-

손흥민 악착같이 붙잡았어야지…토트넘 나락으로 떨어졌다, FA컵 조기 탈락→감독 경질 가능성 거론
(엑스포츠뉴스 김환 기자) 토트넘 홋스퍼가 나락으로 떨어졌다. 올시즌 잉글리시 프리미어리그(EPL)에서 부진을 겪고 있는 토트- 2026-01-12 07:00
- 엑스포츠뉴스
-

쿠팡발 집단소송제 도입 탄력…“상법 개정하듯 저항 돌파해야”
경제활동 인구보다 많은 3370만명의 개인정보를 유출하고도 무책임하게 나오는 쿠팡에 대한 소비자의 분노가 거세다. 미국에 본사- 2026-01-12 07:00
- 한겨레
-

“정부 곳간 채우는 과징금 대신 ‘피해구제기금’ 만들자”
‘과징금은 쌓여가는데, 왜 피해자는 제대로 배상받지 못하는가.’ 최근 에스케이텔레콤(SKT), 케이티(KT), 쿠팡 등 대형- 2026-01-12 07:00
- 한겨레
-

창원·부산 용틀임…성낙송 부활, 박건이·장우준 존재감 과시 [경륜]
광명스피돔에서 새해 첫 경주를 알리는 총성과 함께 본격적인 2026시즌 막이 올랐다. 지난 시즌 경륜 중심축은 임채빈(25기,- 2026-01-12 07:00
- 쿠키뉴스

